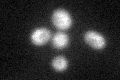

View description
Plasma membrane riboflavin transporter; facilitates the uptake of vitamin B2; required for FAD-dependent processes; sequence similarity to mammalian monocarboxylate permeases, however mutants are not deficient in monocarboxylate transport
Localization:
Intensity:
Fold change:
Significance:
-
C’ GFP library in SD

below threshold15.79 -
N' NOP1pr-GFP in SD

N/A0 -
N' TEF2pr-mCherry in SD

N/A0 -
N' NATIVEpr-GFP in SD

N/A0 -
N' TEF2pr-VC and Cyto-VN in SD

N/A0 -
C’ GFP library in SD+DTT
cytosol19.471.23No -
C’ GFP library in SD+H2O2

cytosol16.781.06No -
C’ GFP library in Starvation Media

cytosol18.721.18No -
C’ GFP library on the background of Pup2-DaMP

below threshold -
C’ GFP library on the background of CCT mutant

below threshold15.85221.00329No
